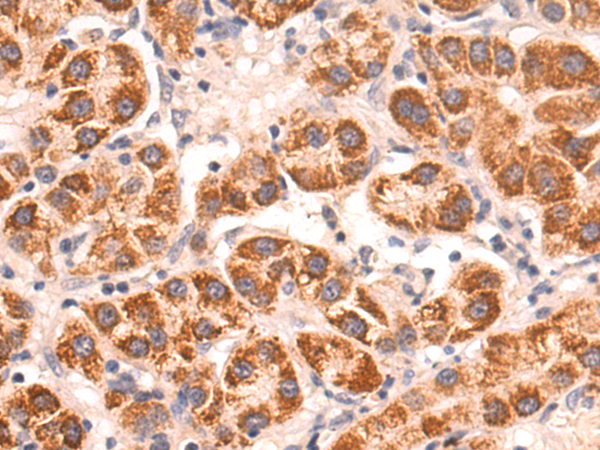

-
分类: 科研抗体货号: P05786别名:应用: WB,IHC反应种属: Human, Mouse, Rat
-
分类: 科研抗体货号: P05854别名: HUAT; LGALS9A应用: WB,IHC反应种属: Human, Mouse, Rat
-
分类: 科研抗体货号: P05884别名: IGFR; CD221; IGFIR; JTK13应用: IHC反应种属: Human, Mouse, Rat
-
分类: 科研抗体货号: P05848别名: FRP-2; SARP1; SDF-5应用: IHC反应种属: Human, Mouse
-
分类: 科研抗体货号: P05871别名: HOX4; HOX4D; HOX4E; Hox-4.4应用: WB,IHC反应种属: Human, Mouse
-
分类: 科研抗体货号: P05847别名: TMP; CL-20; EMP-1应用: IHC反应种属: Human
-
分类: 科研抗体货号: P05866别名: HOX2; HU-1; HOX2A; Hox2.1; HHO.C10应用: WB反应种属: Human, Mouse
-
分类: 科研抗体货号: P05845别名: DLK-2; EGFL9应用: IHC反应种属: Human, Mouse, Rat
-
分类: 科研抗体货号: P05861别名: GAR22应用: IHC反应种属: Human, Mouse
-
分类: 科研抗体货号: P05917别名:应用: IHC反应种属: Human, Mouse

鄂公网安备42018502007531号
鄂公网安备42018502007531号

